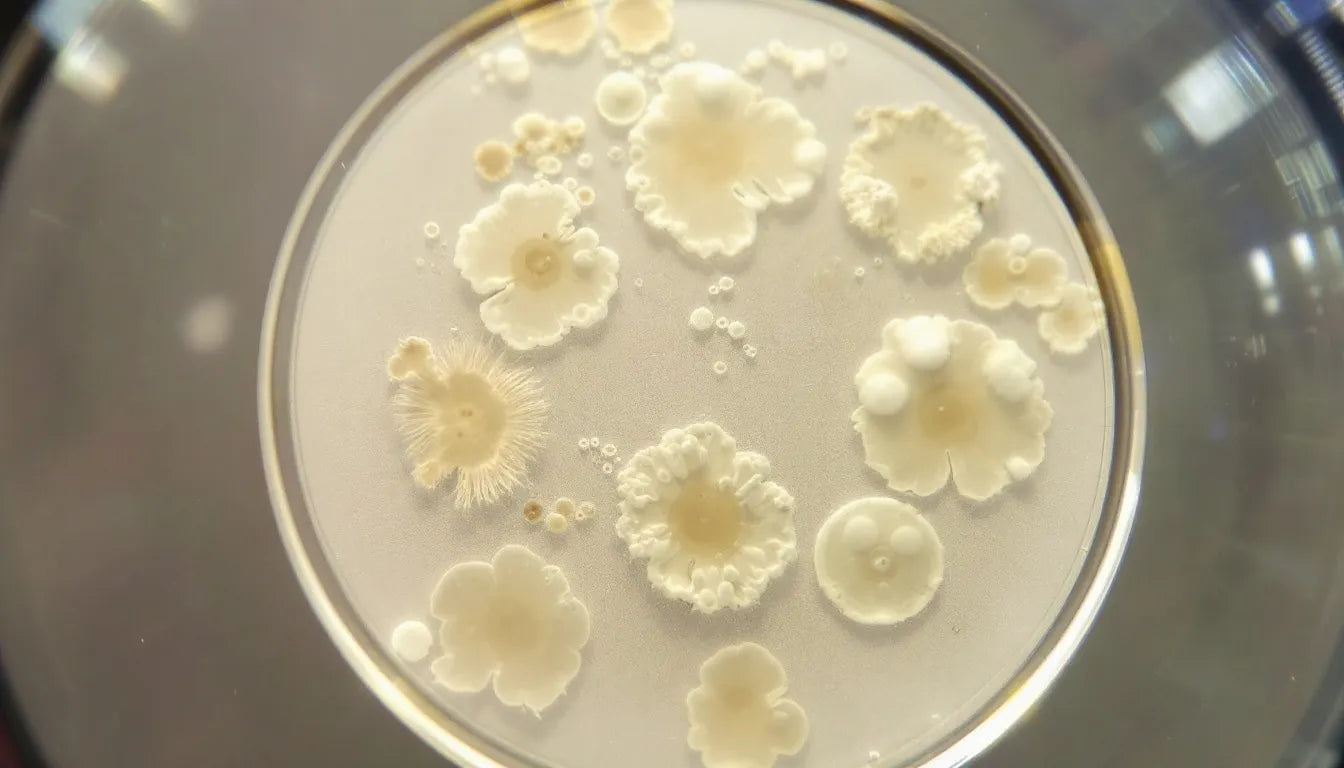
Psilocybin mushroom spore prints on glass microscope slides

⬇️ Prefer to listen instead? ⬇️

- 🧠 Psilocybin remains a Schedule I drug in Alaska, making possession and cultivation illegal, but spores are legal if not grown.
- 💊 Ketamine is legal for medical use in Alaska and widely used for treatment-resistant depression and PTSD.
- 🧪 Over 70 clinical trials currently study the therapeutic use of psychedelics like psilocybin and MDMA across the U.S.
- ⚠️ There are no active psychedelic decriminalization efforts in Alaska as of 2023, unlike Oregon or Colorado.
- 📉 Alaska aligns with federal drug laws, meaning psychedelics are generally treated with stricter enforcement measures.

Psychedelics and the Law in Alaska: What the Law Says
Even though many people across the country are interested and science shows their benefits, the legal rules for psychedelics in Alaska are strict. Alaska is often thought of as a state that's open to natural substances, because it legalized cannabis early. But psychedelics like psilocybin, MDMA, LSD, and some natural substances are still mostly against the law here. This article looks at psychedelic laws in Alaska right now. It covers what's legal, new research, and how laws might change later.
⚠️ Disclaimer: This article is provided for educational and informational purposes only. Zombie Mushrooms does not condone, encourage, or promote the use of psychedelics. We are a legal mushroom cultivation supply company, and all of our products are intended strictly for gourmet and medicinal mushroom growing.

Understanding Psychedelics: What Are They and Why Are They Regulated?
Psychedelics are chemicals that strongly change how people see things, how they feel, and how they think. They are often called "hallucinogens." Psychedelics can make people feel very clear about their emotions, or like their sense of self fades away. They can also cause visual or auditory hallucinations. When used as medicine, these experiences are believed to help people heal. They let people deal with trauma, depression, or addiction from new points of view.
Common psychedelics include:
- Psilocybin: Found naturally in magic mushrooms, especially species like Psilocybe cubensis.
- LSD (Lysergic Acid Diethylamide): A potent synthetic hallucinogen produced from ergot fungus.
- MDMA (3,4-Methylenedioxymethamphetamine): An empathogen commonly used in clinical studies for PTSD.
- Ketamine: A dissociative anesthetic with psychedelic properties, now legally used in mental health clinics.
For decades, U.S. law put these substances into the Schedule I controlled substances group. The law said they have no accepted medical use and a high chance of abuse. However, recent science tells a different story. More than 70 clinical trials on ClinicalTrials.gov are currently studying how psilocybin and MDMA might help treat illnesses (NIH, 2021). This changing research is changing how people think about them and affecting talks about drug laws.

Psilocybin & Magic Mushrooms in Alaska
One of the most talked about psychedelics today is psilocybin, the active compound in “magic mushrooms.” Some places in the U.S. have started to decriminalize or even legalize psilocybin for certain uses. But Alaska is still very strict about it.
Legal Classification
Psilocybin remains a Schedule I substance under both state and federal law, meaning:
- There is officially “no currently accepted medical use in treatment.”
- It has a “high potential for abuse.”
- Severe penalties can apply for possession, distribution, or cultivation.
What This Means for Alaskans
In practice, this means:
- Personal possession of psilocybin mushrooms is illegal and can result in arrest and felony charges.
- Growing magic mushrooms, even for your own use or for treatment, is against the law, as stated in Alaska Statutes § 11.71.140 – 11.71.190.
- Selling or gifting mushrooms is prosecuted harshly and could result in both state and federal charges.

LSD Legality in Alaska
LSD, another potent hallucinogen made famous during the 1960s counterculture movement, is entirely illegal in Alaska.
Drug Scheduling
- Federal and state classification: Schedule I
- Meaning: No recognized medical use, high abuse potential, and severe legal penalties
Legal Risks
Possessing even a microdose of LSD in Alaska:
- Counts as criminal possession of a controlled substance.
- Can lead to felony charges.
- Brings consequences ranging from hefty fines, long-term imprisonment, and a criminal record.
Reform Status
Unlike psilocybin and MDMA, LSD is largely absent from medical trials and reform efforts. Even though people still use it and share stories, no legal exceptions or pilot studies are happening in Alaska or nationwide.

MDMA in Alaska: From Party Drug to Mental Health Treatment
MDMA was once known as a recreational “club drug.” Now, it's a major part of serious mental health research. This is especially true for its important effect on treating Post-Traumatic Stress Disorder (PTSD).
Legal Status: Still Schedule I
Like psilocybin and LSD, MDMA is categorized as a Schedule I substance under Alaska law, making:
- Recreational use, possession, and distribution illegal and punishable by law
- Home therapies or unsupervised trials completely prohibited
Growing Medical Acceptance
Even though it's illegal, clinical trials funded by organizations like MAPS (Multidisciplinary Association for Psychedelic Studies) have shown strong results:
- A landmark Phase 3 trial published in Nature Medicine showed 67% of participants with severe PTSD no longer qualified for the diagnosis after MDMA-assisted therapy.
- The FDA has granted “breakthrough therapy” status to MDMA for PTSD. This is speeding up how it's reviewed and approved.
Alaska’s Position
Currently, there are no FDA-sanctioned MDMA clinics operating in Alaska under expanded access or compassionate use programs. However, federal approval could open the door to legal use in the state within a few years.

Ketamine: An Exception to the Rule for Alaskans
Among the psychedelic compounds discussed, ketamine stands apart as the only one with legal medical use in Alaska and the U.S.
Legal Status
-
It is a Schedule III substance, which means it has:
- Accepted medical use
- Moderate risk of dependence or abuse
FDA Approval
In 2019, the FDA approved esketamine, a nasal spray form of ketamine, for treatment-resistant depression (FDA, 2019). It is available only through:
- REMS-certified providers
- Administered under medical supervision
- Typically part of an integrated therapeutic program
Clinical Use in Alaska
Ketamine therapy clinics in Alaska offer services like:
- IV infusions of racemic ketamine
- Spravato (esketamine) nasal spray
- Guided psychotherapy integration of ketamine sessions
This makes ketamine the only psychedelic currently available to Alaskans through legal medical channels.

Decriminalization vs. Legalization: What Alaskans Need to Know
One of the most confusing things about drug laws is the difference between decriminalization and legalization, especially when looking at psychedelic laws in Alaska.
Decriminalization
- Removes criminal penalties for personal use and possession
- May still involve civil fines or forfeitures
- Often reflects law enforcement deprioritization
Legalization
- Completely removes legal penalties
- Allows for regulated sales, distribution, and use
- Similar to Alaska’s cannabis law model, passed in 2015
Alaska has neither decriminalized nor legalized any psychedelic substances beyond specific medical use of ketamine.

Federal vs. State Jurisdiction: Why Alaska Follows Federal Drug Laws
Alaska mirrors federal drug scheduling in its own statutes, which means:
- All Schedule I substances under federal law remain Schedule I under Alaska law.
- Without active state reforms, federal policy largely dictates legality.
In Oregon and Colorado, local and state ballot initiatives have successfully deprioritized enforcement despite ongoing federal prohibition. Without similar initiatives, Alaska remains fully compliant with federal drug law.

Psychedelic Reform Activity in Alaska: Is There Any Change?
While the U.S. sees waves of reform, Alaska remains inactive in psychedelic legislation. Here's where things stand:
- No local advocacy groups are pushing decriminalization or medical access of psychedelics.
- No legislative proposals for entheogen access exist in the Alaska legislature.
- Talk in local media on the topic is still rare.
Alaska’s pathway may be influenced more by national shifts than internal pressure.
Mycology Enthusiasts: Legal Cautions and Safe Routes in Alaska
For Alaskans interested in growing mushrooms for research or learning about natural fungi:
Legal Spore Study
- Psilocybin mushroom spores are not illegal, as they contain no psychoactive compounds.
- Spores are often sold as “for microscopy use only” products.
Legal Risks Begin at Cultivation
- Cultivating these spores into mushrooms containing psilocybin breaks Alaska drug laws.
- Getting caught could result in felony charges, even if the mushrooms are for personal use.
Best Practices
- Stay within research-only intentions.
- Avoid germination or fruiting of any psychoactive species.
- Check with trusted spore vendors about which strains are legal where you live.

Scientific Research: What Drives Future Psychedelic Laws
Shifting laws are deeply influenced by rigorous science. Landmark studies from top institutions have shown:
- Johns Hopkins: Psilocybin-assisted therapy reduced major depressive symptoms by over 50% after four weeks.
- NYU & Imperial College London: Patients with terminal illness experienced reduced anxiety and improved quality of life.
- MAPS: MDMA reduced PTSD symptoms significantly in veterans and frontline workers.
Alaskans are likely to see reform only after controlled research leads to changes in national rules, such as potential FDA rescheduling.

National Psychedelic Trends and What They Mean for Alaska
The lack of reform in Alaska contrasts sharply with movement in other states:
- Oregon: First state to create regulated psilocybin therapy centers.
- Colorado: Decriminalized natural entheogens and started creating advisory boards for psychedelics.
- Local cities: Oakland, Denver, and Seattle have deprioritized enforcement for psychedelics.
These models may create ways of doing things Alaska could use later, especially if federal law changes first.
What's Next for Psychedelics in Alaska
As of 2025, psilocybin legality in Alaska remains strict, with magic mushrooms illegal despite growing national interest. But there are legal ways for ketamine therapy, and legal research through spore study is still possible. While no new laws are being pushed for change right now, the way things are going in the U.S. and new scientific discoveries suggest Alaska’s stance could change. This is especially true in the area of mental health. Until then, staying informed, cautious, and compliant will be key.
🍄 Ready to learn more about legal mushroom strains and stay ahead of Alaska’s changing psychedelic situation? Subscribe to Zombie Mushrooms for updates, spore growing tips, and information based on science, along with legal safety advice.
Citations
- U.S. Drug Enforcement Administration. (2022). Drug Scheduling. https://www.dea.gov/drug-information/drug-scheduling
- National Institutes of Health. (2021). ClinicalTrials.gov Database. https://clinicaltrials.gov
- Alaska Statutes § 11.71.140 – 11.71.190 (2022).
- Food & Drug Administration (FDA). (2019). FDA Approves New Nasal Spray Medication for Treatment-Resistant Depression. https://www.fda.gov/news-events/press-announcements/fda-approves-new-nasal-spray-medication-treatment-resistant-depression



